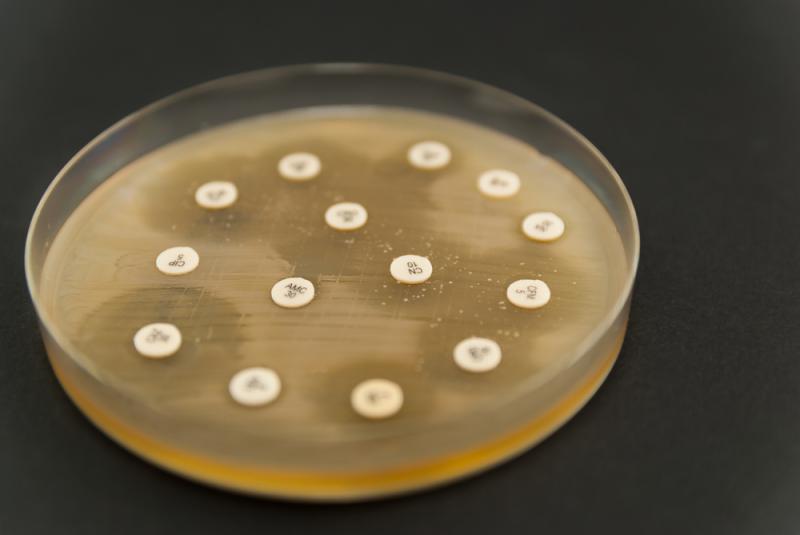

antybiotyk
Antybiotyk — Antybiotyk – substancja chemiczna wytwarzana naturalnie przez organizmy żywe, głównie drobnoustroje (bakterie i grzyby) bądź otrzymywana syntetycznie. Antybiotyk hamuje procesy życiowe drobnoustrojów chorobotwórczych lub prowadzi do ich śmierci. Antybiotyki wykorzystywane są w medycynie w leczeniu zakażeń bakteryjnych, leczeniu nowotworów oraz jako lek immunosupresyjny.
Historia antybiotyków
Antybiotyk (gr. anti – przeciw; -bios – życie) jest substancją pochodzenia biologicznego bądź otrzymywaną syntetycznie, która w stosunku do mikroorganizmów (głównie bakterii chorobotwórczych) wykazuje właściwości bakteriostatyczne (hamuje procesy życiowe bakterii – wzrost, metabolizm, podziały komórkowe) lub bakteriobójcze (prowadzi do śmierci komórek bakteryjnych). Wytwarzana jest przez niektóre gatunki grzybów (penicylina), promieniowców (streptomycyna), bakterii (gramicyna) oraz przez rośliny (fitoncydy). Antybiotyki wykorzystywane są w leczeniu zakażeń bakteryjnych, leczeniu nowotworów oraz jako lek immunosupresyjny.
Pierwszy antybiotyk, penicylina, wytwarzana przez pędzlaki (Penicillium) została odkryta przez szkockiego bakteriologa i lekarza Alexandra Fleminga w 1928 r. Czysta penicylina wyizolowana z Penicillium notatum została wprowadzona do lecznictwa przez australijskiego farmakologa Howarda W. Floreya i brytyjskiego biochemika E. B. Chaina w 1942 r.
Odkrycie penicyliny spowodowało przełom w leczeniu chorób i zakażeń bakteryjnych. Dalsze badania zaowocowały wyodrębnieniem i wprowadzeniem do lecznictwa kolejnych antybiotyków, poznaniem ich budowy chemicznej, mechanizmów działania oraz interakcji z innymi lekami oraz opracowaniem metod półsyntetycznego i syntetycznego otrzymywania tych substancji.
Antybiotyki – rodzaje i mechanizmy działania
Antybiotyki są przeważnie małocząsteczkowymi związkami chemicznymi, cechującymi się skomplikowaną budową. Ze względu na budowę chemiczną wyróżnia się następujące grupy antybiotyków:
- antybiotyki β-laktamowe – antybiotyki posiadające w strukturze cząsteczki pierścień o budowie β-laktamowej; hamujące biosyntezę ścian komórkowych bakterii (hamowanie aktywności transpeptydazy i powstawania wiązań krzyżowych odpowiedzialnych za tworzenie gęsto usieciowanej i sztywnej struktury peptydoglikanu – składnika ściany komórkowej); do grupy tej zalicza się penicyliny naturalne (benzylopenicylina, fenoksymetylopenicylina) oraz półsyntetyczne (kloksacylina, ampicylina, karbenicylina); cefalosporyny (cefaleksyna, cefradyna, cefuroksym, cefazolina); monobaktamy (aztreonam) i karbapenemy (ertapenem).
- antybiotyki peptydowe – antybiotyki o budowie peptydowej; do grupy tej zalicza się bakteriocyny o właściwościach bakteriobójczych; cykliczne antybiotyki polipeptydowe uszkadzające błonę komórkową bakterii gramujemnych (polimyksyny) lub zaburzające procesy energetyczne komórki bakteryjnej poprzez zakłócanie przepuszczalności błony komórkowej (gramicydyny); glikopeptydy hamujące syntezę ściany komórki bakteryjnej (wankomycyna, teikoplanina) oraz lipopeptydy hamujące syntezę białek, DNA i RNA, co prowadzi do śmierci komórki bakteryjnej (daptomycyna).
- antybiotyki aminoglikozydowe – antybiotyki składające się z aminoglikozydów połączonych z aminocyklitolami; uszkadzające błonę komórkową i zaburzające syntezę białek bakteryjnych (hamowanie inicjacji translacji); do tej grupy zalicza się aminoglikozydy I generacji (streptomycyna, neomycyna, kanamycyna) oraz aminoglikozydy II generacji (gentamycyna, amikacyna).
- tetracykliny – antybiotyki zawierające w cząsteczce 4 cykliczne pierścienie; hamujące biosyntezę białka oraz zaburzające procesy energetyczne w komórkach bakteryjnych; do tej grupy zalicza się tetracykliny naturalne (tetracyklina, oksytetracyklina, chlorotetracyklina) i tetracykliny półsyntetyczne (doksycyklina, metacyklina, minocyklina).
- antybiotyki makrolidowe (makrolidy) – antybiotyki o cząsteczce składającej się z pierścienia laktonowego i dołączonych do niego reszt cukrowych; wykazują właściwości bakteriostatyczne polegające na hamowaniu syntezy białek u tlenowych bakterii gramdodatnich oraz niektórych bakterii gramujemnych; do grupy tej zaliczane są erytromycyna i jej pochodne (estolan erytromycyny, etylobursztynian erytromycyny, laktobionian erytromycyny), oleandomycyna, spiramycyna.
Antybiotyki mogą wywoływać niepożądane skutki uboczne – działają toksycznie na nerki (polimyksyny, aminoglikozydy), wątrobę (tetracykliny), ucha wewnętrzne (aminoglikozydy) oraz szpik kostny (chloramfenikol); mogą wywoływać reakcje alergiczne (penicyliny) oraz niszczyć naturalną florę bakteryjną organizmu, co prowadzi do zaburzeń trawienia, awitaminozy oraz zwiększonej podatności na nadkażenia.

Antybiotykooporność
Antybiotykooporność (oporność na antybiotyki) jest narastającym zjawiskiem braku wrażliwości drobnoustrojów chorobotwórczych na antybiotyki stosowane w przebiegu zakażenia lub choroby, co ogranicza możliwości leczenia przez ciągłe zmniejszanie się liczby skutecznych antybiotyków.
Drobnoustroje chorobotwórcze wykazują antybiotykooporność naturalną (polegającą m.in. na braku możliwości penetracji antybiotyków przez ścianę komórkową, wytwarzaniu enzymów hydrolizujących antybiotyki, niskim powinowactwie antybiotyków do receptora) oraz antybiotykooporność nabytą (polegającą na nabyciu genów oporności od innych bakterii na drodze transferu pionowego lub poziomego bądź wskutek spontanicznych mutacji).
Antybiotykooporność drobnoustrojów chorobotwórczych bardzo często wiąże się z powszechnym używaniem antybiotyków w lecznictwie oraz nadmiernym wykorzystywaniem tych substancji w przemyśle spożywczym.


